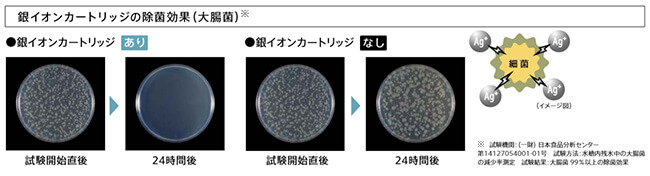

リンナイのおすすめ食洗機をご紹介
リンナイ ビルトイン食洗機のシリーズ一覧
スライドオープン型 ミドルタイプ


スライドオープン型 ディープタイプ


フロントオープンタイプ


関連部材
リンナイ ビルトイン食洗機の選び方
スライドオープンかフロントオープンか選ぶ
「スライドオープン」と「フロントオープン」は扉の開き方の違いです。最近のビルトイン食洗機の主流はスライドオープンタイプですが、現在フロントオープンタイプをお使いのお客様からは、続けてフロントオープンをご希望されるケースもございます。
ドアの開け閉めなど、体への負担を軽減したい方はスライドオープン、食器のセットのしやすさ・庫内の広さを優先したい方はフロントオープンタイプをおすすめいたします。
スライドオープンタイプ

スライドオープンのメリットは、腰をかがめずに食器のセットができるため、体への負担が少なく、食器セット時に周囲に水が飛び散らないことです。
浅型のミドルタイプと、深型のディープタイプの2種類があり、ディープタイプの方が庫内が大きいので、大きなお鍋やフライパンも収納することができます。
また、重曹洗浄機能や、プラズマクラスターが搭載された機種、スチーム洗浄できる機種など、フロントオープンタイプに比べ、ラインナップが豊富なため、必要な機能に合わせて機種を選ぶことができます。
フロントオープンタイプ

フロントオープンタイプは、1990年代~2000年にかけての主流のタイプで、ドアを手前に引き倒すように開閉するタイプです。
フロントオープンのメリットは、食器の出し入れのしやすさ、収納庫内を広く使えることです。正面から食器をセットでき、下カゴの食器を取り出す際も、上カゴの食器を取り出す必要がありません。
庫内の容積も広く、鍋などの調理器具のセットも可能です。
当社では8割以上のお客様が「スライドオープン」タイプを選んでいます。
食洗機の発売当初はフロントオープンしかありませんでしたが、機能性や商品バリエーションの豊富さから現在はスライドオープンが主流となっています。
今までフロントオープンを使っていて従来の使い勝手を変えたくないという方以外は「スライドオープン」タイプをおすすめしています。
スライドオープンの場合:ミドルタイプかディープタイプか選ぶ
リンナイのスライドオープンタイプの食洗機には、浅型のミドルタイプと、深型のディープタイプの2種類があります。大きな違いは庫内の大きさで、ディープタイプはミドルタイプに比べて庫内が大きいので、大型の鍋やフライパンなども洗うことができます。
なお、現在、食洗機の下に収納が設置されている場合、ミドルタイプの食洗機であることがほとんどです。リンナイのディープタイプ食洗機の下には収納を設置することができないため、現在ミドルタイプをお使いの場合は同じくミドルタイプへの交換がおすすめです。
ミドルタイプ

ディープタイプ

スライドオープンの場合:おかってカゴかぎっしりカゴか選ぶ
リンナイのスライドオープンタイプの食洗機は、より多くの食器を収納できる【ぎっしりカゴ】と、食器の入れやすさ重視の【おかってカゴ】の2種類があります。
同じ食器カゴタイプでも機種により「食器収納点数」や「ピン形状」「上カゴ」など仕様が異なりますので、各カゴ形状別に食洗機タイプ(ディープタイプ・ミドルタイプ)、グレード(ハイ・ミドル・ベーシック)ごとの仕様をまとめた下記一覧をご確認いただき、ご希望や使い勝手にあった商品をお選びください。
一度にたくさんの食器を収納できる「ぎっしりカゴ」
ラック全体のピンの配置を工夫したことにより、食器をぎっしり収納できる「ぎっしりカゴ」は、一度にたくさんまとめて洗いたい人向けの食器カゴです。ディープタイプとミドルタイプで「食器収納点数」や食器を固定する「ピン形状」「上カゴ仕様」が異なります。

食洗機別「ぎっしりカゴ」仕様一覧
タイプ | ミドルタイプ(浅型) | ディープタイプ(深型) | ||||
---|---|---|---|---|---|---|
グレード | ハイグレード | ミドルグレード | ベーシックグレード | ハイグレード | ミドルグレード | ベーシックグレード |
代表品番 | RSW-405LP | RSW-405GP | RSW-405AA-SV | RSW-SD401LPA | RSW-SD401GPA | RSW-SD401A-SV |
食器収納 | 約5人分 40点 | 約6人分 47点 | ||||
ピン形状 | 幅広のピン形状
![]() 高さ20mm、左右のピンをM字につなげた新形状のピンで入れやすさがさらに向上しました。 |
従来の左右ピン
![]() 高さ7mmの左右ピンでいろいろな深さの食器をひっかけやすくセットしやすくなっています。 |
||||
上カゴ | 左右分割折りたたみサークルラック
![]() 左右に分割して折りたたむことができます。下カゴに入れた食器が干渉してしまう部分だけを折りたたみ、コップなどを一緒に洗うことができます。左右一緒にたたむこともできます。 |
サークルラック
![]() 折りたためません。 |
折りたたみサークルラック
![]() 用途にあわせて折りたたむことができます。上カゴを外さずに下カゴの奥にもセットできるのでとても便利です。 |
サークルラック
![]() 折りたためません。 |
||
フリーラック ※上カゴ手前のラック ![]() |
あり
![]() 入れるものにあわせて、ラックの状態が6パターンに変更できます。 |
― | あり
![]() 入れるものにあわせて、ラックの状態が4パターンに変更できます。 |
― |
食器の入れやすさを重視した「おかってカゴ」
ぎっしりカゴより食器収納点数は少なくなりますが、形や大きさがの違う食器が多く入れやすさを重視する人向けの食器カゴです。一番のポイントは、下カゴの3列のピンをそれぞれ自由にスライドできる点です。入れたい食器のサイズに合わせてピン位置を調節できる可動式レール搭載で、セットのしやすさが格段にアップします。

食洗機別「おかってカゴ」仕様一覧
タイプ | ミドルタイプ(浅型) | ディープタイプ(深型) | |||
---|---|---|---|---|---|
グレード | ハイグレード | ミドルグレード | ハイグレード | ミドルグレード | ベーシックグレード |
代表品番 | RSW-405LPE | RSW-405GPE | RSW-SD401LPEA | RSW-SD401GPEA | RSW-SD401AE-SV |
食器収納 | 約4人分 30点 | 約4人分 37点 | |||
下カゴ | 幅広のピン形状
![]() 高さ20mm、左右のピンをM字につなげた新形状のピンで入れやすさがさらに向上しました。 |
従来の左右ピン
![]() 高さ7mmの左右ピンでいろいろな深さの食器をひっかけやすくセットしやすくなっています。 |
|||
可動式レール
![]() ピンの位置をスライドすることができるので、食器の大きさや形にあわせてセットがしやすい食器カゴです。 |
可動式レール
![]() ピンの位置をスライドすることができるので、食器の大きさや形にあわせてセットがしやすい食器カゴです。 |
― | |||
上カゴ | 左右分割折りたたみサークルラック
![]() 左右に分割して折りたたむことができます。下カゴに入れた食器が干渉してしまう部分だけを折りたたみ、コップなどを一緒に洗うことができます。左右一緒にたたむこともできます。 |
サークルラック
![]() 折りたためません。 |
|||
フリーラック ※上カゴ手前のラック ![]() |
あり
![]() 入れるものにあわせて、ラックの状態が6パターンに変更できます。 |
― | あり
![]() 入れるものにあわせて、ラックの状態が4パターンに変更できます。 |
― |
シンク下設置の場合:リンナイRSWA-C402CAがおすすめ
シンク下にビルトイン食洗機を設置する場合、奥行き寸法が重要になります。シンク下のスペースには、シンクの排水管等があり、通常の設置場所よりも奥行きが狭くなるため設置できる機種が限られます。
リンナイのビルトイン食洗機「RSWA-C402CA」は、スペースが限られているシンク下キャビネット内の奥行が55cm以上(扉の厚みは含めず)あれば設置が可能なコンパクトタイプ。排水接続部材や目隠し用のフィラーもセットになっているので、シンク下に新規設置の場合はこちらの商品がおすすめです。

なお、奥行寸法を満たしていても現在ご使用いただいているキッチンの仕様によっては、設置ができない場合もございます。お見積り依頼の際に、設置予定場所のお写真をお送りいただけましたら、専門スタッフにて設置可否を判断いたしますが、お客様ご自身でまずご判断されたい場合は、下記ページをご参照ください。
■ご自宅のシンク下に設置できる機種を確認する
【交換】シンク下にある幅45cm食洗機の交換可能な機種を確認する>
【新規設置】シンク下に幅45cmの食洗機を新規設置・後付けできる機種を確認する>
シンク下設置対応機 RSWA-C402CA

※カゴタイプは、ぎっしりカゴです。

リンナイ ビルトイン食洗機の特長
プラズマクラスターによる除菌機能はリンナイだけ!

プラズマクラスターは、空気中の水と酸素からプラスイオンとマイナスイオンを作り、空気の洗浄やカビ菌の除去をします。この方法は、自然界と同じ空気浄化システムのため、体への影響も無く安心です。

洗浄直後のクリーンな状態をキープ
食器の乾燥時に、プラズマクラスターイオンが食洗機の外から取り込まれる空気を浄化。食洗機庫内の浮遊カビ菌の分解・除去に加え、付着カビ菌の増殖も抑制し、食洗機庫内の気になるニオイを抑える消臭効果もあります。
また、手洗いで食器を洗浄後、食洗機を食器保管庫としてご使用される場合は「クリーンキープコース」で保管スでば、清潔さを保つことができます。

ミドルタイプ:RSW-405LP RSW-405LPE RSW-405GP RSW-405GPE
ディープタイプ:RSW-SD401LPA RSW-SD401LPEA RSW-SD401GPA RSW-SD401GPEA
天然由来の重曹洗浄で人にも自然にもお財布にもやさしい!

体にも環境にも優しい重曹洗浄ですが、ひどい油汚れがついた食器や調理器具の洗浄は苦手なため、その場合は専用洗剤で高温洗浄するか、予洗いするのが効果的です。重曹のみで油汚れを落としたい場合は、あらかじめ食器や鍋に重曹をふりかけて数分おき、油を浮かせてから食洗機にセットすると汚れが落ちやすくなります。
※重曹と専用洗剤と2つのモードの使い分けが可能です。食器の種類や状況に合わせてご選択ください。

重曹洗浄コースはランニングコストも割安!
重曹洗浄コースは、重曹が効果を発揮する約30℃程度の低温で洗浄するため、従来と比べて光熱費が抑制できます。1回当たりのランニングコストは約35.7円と、手洗いの場合の半分近く、年間で約18,800円もおトクです。専用洗剤で洗浄する場合と比べても経済的な重曹洗浄は、使うほど家計にやさしい、節約上手な洗浄方法です。

● RSW-D401LP「重曹コース」で洗った場合(20℃給水接続) ●手洗い:洗い桶に40℃のお湯10Lをためて洗った後、毎分6L・12.8分間すすぎ洗いした場合 算出基準料金(税込) ○水道料金:137円/m3(税込) ○下水道使用料:125円/m3(税込)〔日本電機工業会調べ〕 ○電力料金目安単価31円/kWh(税込)【2022年7月改定】 〔家電公取協調べ〕○ガス料金(都市ガス):167円/m3(税込) <リンナイ社調べ> ○食器洗い乾燥機専用洗剤代:422円(税込)/1箱(600g)<リンナイ社調べ> ○重曹:440円/800g〔リンナイ社調べ〕 ○手洗い用洗剤代:164円/315mL〔日本電機工業会調べ〕(2022年7月時点)1日2回使用した場合の365日で算出。
ミドルタイプ:RSW-405LP RSW-405LPE RSW-405GP RSW-405GPE
ディープタイプ:RSW-SD401LPA RSW-SD401LPEA RSW-SD401GPA RSW-SD401GPEA
銀イオンの除菌効果で食器も食洗機庫内も清潔に!

※銀イオンカートリッジの交換時期は、使用開始から2年です。(毎日2回標準コースで365日使用した場合)交換時期を過ぎると除菌・抗菌効果がなくなります。
ミドルタイプ:全機種、シンク下対応機:RSWA-C402CA
ディープタイプ:全機種
優れた省エネ性!自動で節水、節電してくれるエコギア!
庫内温度センサーと排気温度センサーのダブルのセンサーで自動で省エネしてくれる「エコギア」。
庫内温度センサーで庫内の食器量を自動で判別し、食器量にあわせてすすぎの回数を調整するなど自動で節水します。また、排気温度センサーでは、排気温度をチェックし、乾燥時のヒーターを制御して庫内の温度を最適に保ち電気代を抑えることができます。
エコギアの作動により、水道使用量を最大約24%、電気使用量を最大約4%抑えることができます。

ミドルタイプ:RSW-405LP RSW-405LPE
ディープタイプ:RSW-SD401LPA RSW-SD401LPEA
リンナイ ビルトイン食洗機 お客様の声
当社でリンナイの食洗機をご購入されたお客様からお寄せいただいた「お客様の声」の一部をご紹介させていただきます。
ビルトイン食洗機交換の流れ
1 Step1. 商品を選ぶ


交換されたい食洗機をお選びください。当社にてお客様にあった商品をご案内することも可能です。
2 Step2. 見積りをご依頼


食洗機が決まったら見積りをご依頼ください。現行の画像をお送りいただければ、設置適合確認も当社で行います。
3 Step3. ご注文


見積りの内容にご納得いただいたらご注文手続きをお願いいたします。工事日程のご希望をお伺いします。
4 Step4. 工事お伺い


工事担当が商品を持って、お客様のご自宅へお伺いし、交換工事一式(本体取り付け及び給水・排水管接続、電気配線接続、試運転等)を行います。